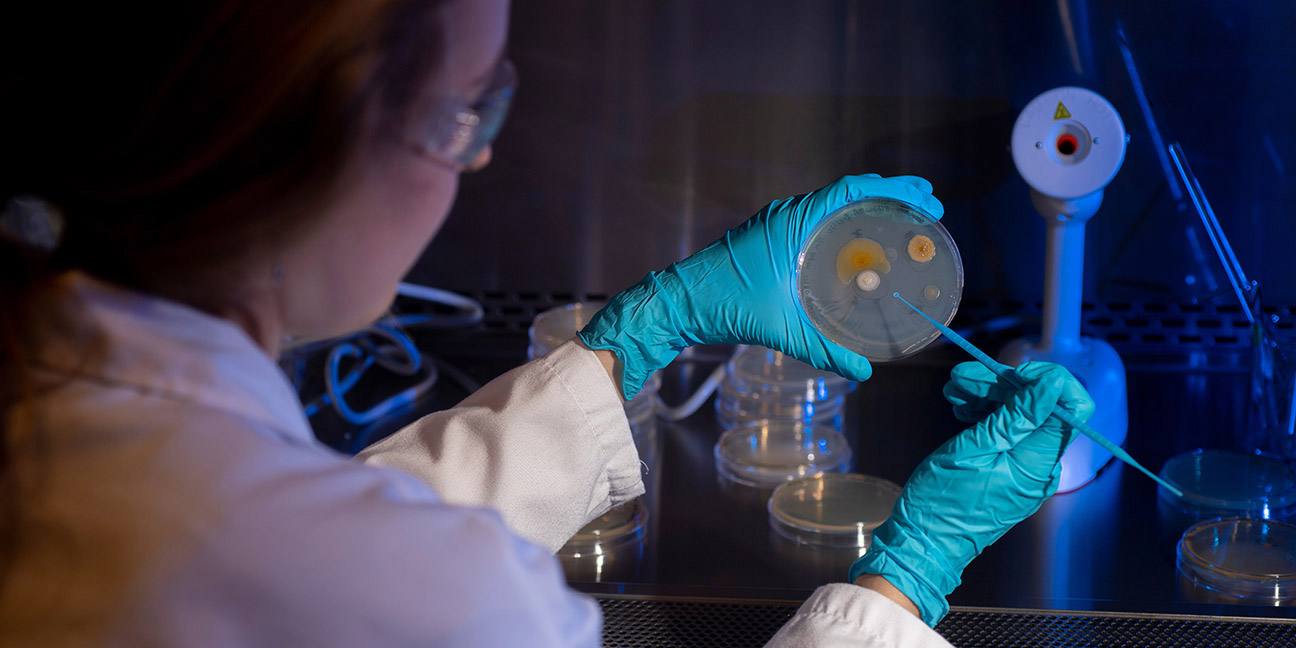

Environmental Science, B.S.
Focus on environmental issues and solutions.
Oceanography, B.S.
Study ocean processes and prepare for marine related careers.
Assess and advise on matters related to the management of environmental issues.
Research aquatic systems for state and federal agencies.
Prepare for a career in science education.
A variety of government agencies need skilled marine biologists to conduct research and advise on policy.
Prepare for careers in pharmaceutical research and development.

Understand core biological content and issues knowledge
Present biological information orally and critique biological literature
Utilize biological literature to examine scientific questions
Demonstrate competence in biological writing
Understand basic biological experimental design and quantitative methods, apply biological and knowledge to current topics
“ The department has a wide array of interests, especially centered around the marine environment, that cultivate a rich academic community. With the addition of very friendly faculty and students, it's a hard place to leave. ”
Focus on environmental issues and solutions.
Study ocean processes and prepare for marine related careers.
Develop an in-depth knowledge of marine ecology along with applied practical training and a greater understanding of life in oceans and coastal waters
Gain a better understanding of how marine systems and processes function under natural and changing conditions to address marine resources and coastal environmental issues